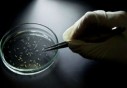

Des chercheurs américains ont découvert des indications selon lesquelles une neuvième planète, très grande, existerait dans notre système solaire, ont-ils indiqué mercredi.L'objet, baptisé «Neuvième planète», aurait une masse d'environ dix fois celle de la Terre et serait sur une orbite vingt fois plus éloignée que celle de Neptune, qui évolue autour du soleil à une distance moyenne de 4,5 milliards de kilomètres.
En fait cette planète effectuerait une orbite complète autour du soleil entre 10.000 et 20.000 ans, précisent ces chercheurs, Konstantin Batygin et Mike Brown, de l'Institut de technologie de Californie (Caltec), qui ont fait cette découverte par la biais de modèles mathématiques et de simulations par ordinateur.
Si l'existence de cet objet, qui n'a pas été observée directement, était confirmée, il serait «la neuvième planète» de notre système solaire, a relevé Mike Brown, un professeur d'astronomie planétaire. «Il n'y a eu jusqu'à présent que deux planètes découvertes dans notre système solaire depuis l'antiquité et ce serait dans ce cas la troisième», a-t-il dit. «Il y a encore une grande partie de notre système solaire qui reste à découvrir et c'est très exaltant», a poursuivi l'astronome.
Pluton a longtemps été considérée comme la neuvième planète du système solaire, mais a perdu ce statut car elle était trop petite.Elle est désormais classée comme une planète naine.La nouvelle planète découverte n'aura pas ce problème: sa masse serait en effet 5.000 fois celle de Pluton.